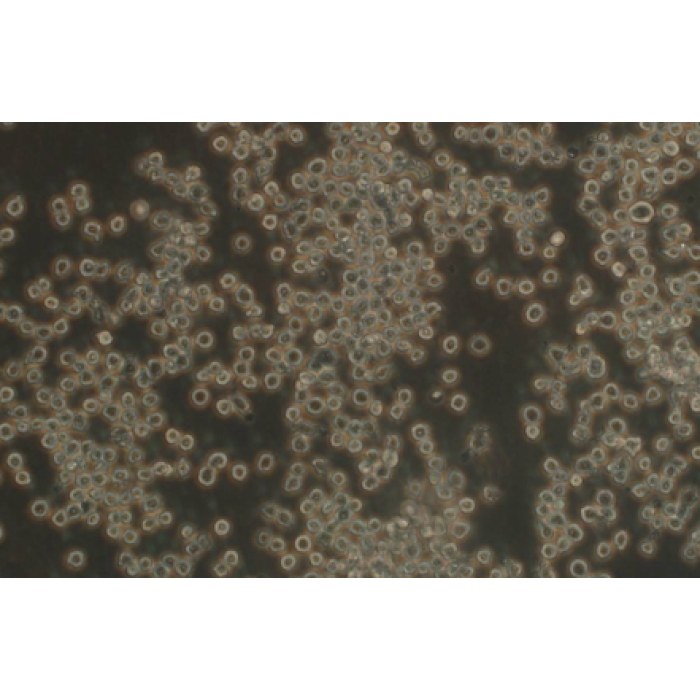

TSINGKE TC‒R0051 ana-1 小鼠巨噬细胞
- 销售价:
- ¥1280.00
- 市场价:
-
¥1600.00 - 编号:
- 202602061097089
- 货号:
- TC‒R0051
-
累计评价
暂无评价
- 月销量: 0
- 评分数: 0
- 评分: 0.0
- 产品规格:
- T25
- 数量:
-
看了又看
推荐商品
-
 ¥5000.00
¥5000.00
¥5000.00Biobw bio-129531 人急性髓系白血病细胞MUTZ-3
1×10⁶cells/T25培养瓶
-
 ¥1440.00
¥1440.00
¥1800.00TSINGKE TC‒H0013 Huh-6 人肝母细胞瘤细胞
-
 ¥1280.00
¥1280.00
¥1600.00TSINGKE TC‒H0211 SF126 人脑星形胶质瘤细胞
-
 ¥1280.00
¥1280.00
¥1600.00TSINGKE TC‒R0016 Yac-1 小鼠白血病细胞NK细胞靶细胞
-
 ¥1280.00
¥1280.00
¥1600.00TSINGKE TC‒H0278 CAL-62 人甲状腺癌细胞(退行性)
商品介绍
英文名字:ana-1
中文名字:小鼠巨噬细胞
生长特征:悬浮
货期:1-2周
培养条件:RPMI 1640(Kinlogix cat:M1002,或Gibco cat:11875,或同配方) 10%胎牛血清
疾病:转化细胞
细胞名称:ana-1 小鼠巨噬细胞
特征特性:暂无
别名:Ana-1; ANA1
形态特征:淋巴母细胞样
种属:小鼠源
组织来源:\
难度等级:★
培养要点:暂无
血清:10%胎牛血清(Kinloigx cat:M301-500)
添加剂:/
1:3传代(培养面积比)
倍增时间:\
消化时间:离心收集(1000rpm,5分钟)
换液频率:每周换液2-3次
冻存液配方:RPMI 1640+10%FBS+10%DMSO
T25培养瓶:1 X 10^6,常温运输
STR信息:N/A


商品参数
| 商品介绍 | |
|---|---|
| 单位 | 瓶 |
| 品牌 | TSINGKE |
商品评论
暂无商品评论信息
商品咨询
暂无商品咨询信息